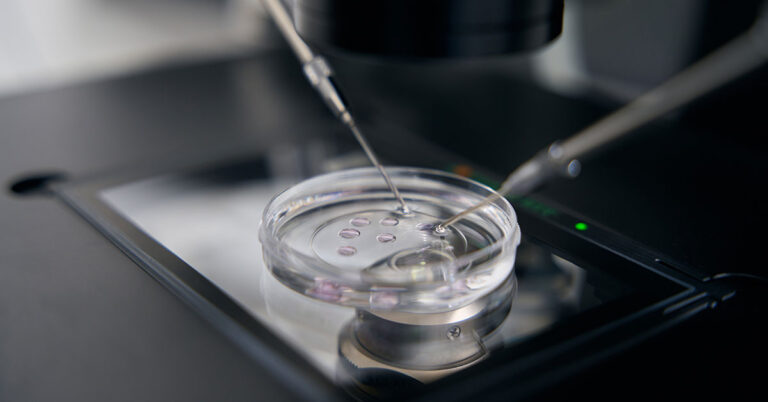

O juiz Federal Carlos Geraldo Teixeira, da 19ª vara Federal Cível de Belo Horizonte/MG, concedeu mandado de segurança para determinar que a Caixa Econômica Federal libere valores do FGTS para custeio de tratamento de fertilização in vitro.
Magistrado ressaltou que a jurisprudência autoriza a interpretação ampliativa das hipóteses de saque do FGTS, sobretudo quando estão em jogo direitos fundamentais, como a dignidade da pessoa humana, a saúde e o planejamento familiar.
A impetrante relatou que teve negado, pela gerente de agência da CEF, o recebimento de requerimento de saque do FGTS destinado ao tratamento de infertilidade, sob o argumento de ausência de previsão no regulamento interno.
Segundo os autos, ela possui 41 anos, diagnóstico de infertilidade e indicação médica para realização de fertilização in vitro como única alternativa viável.
A Caixa alegou que o rol do art. 20 da lei 8.036/90 seria taxativo e não contemplaria a hipótese de saque para fertilização in vitro.
Ao analisar o mérito, o magistrado destacou que a jurisprudência admite interpretação extensiva das hipóteses legais de movimentação do FGTS, especialmente quando envolvem direitos fundamentais, como dignidade da pessoa humana, saúde e planejamento familiar.
Consta da sentença que a infertilidade pode ser equiparada a doença grave para fins de liberação dos valores.
Diante da comprovação da necessidade e da urgência do tratamento, bem como da insuficiência financeira da autora, o juiz julgou procedente o pedido e determinou a imediata liberação de até R$ 36 mil da conta vinculada do FGTS, valor correspondente ao orçamento apresentado para o procedimento, destinado exclusivamente ao custeio da fertilização in vitro.
- Processo: 6384432-37.2025.4.06.3800
Fonte: Migalhas